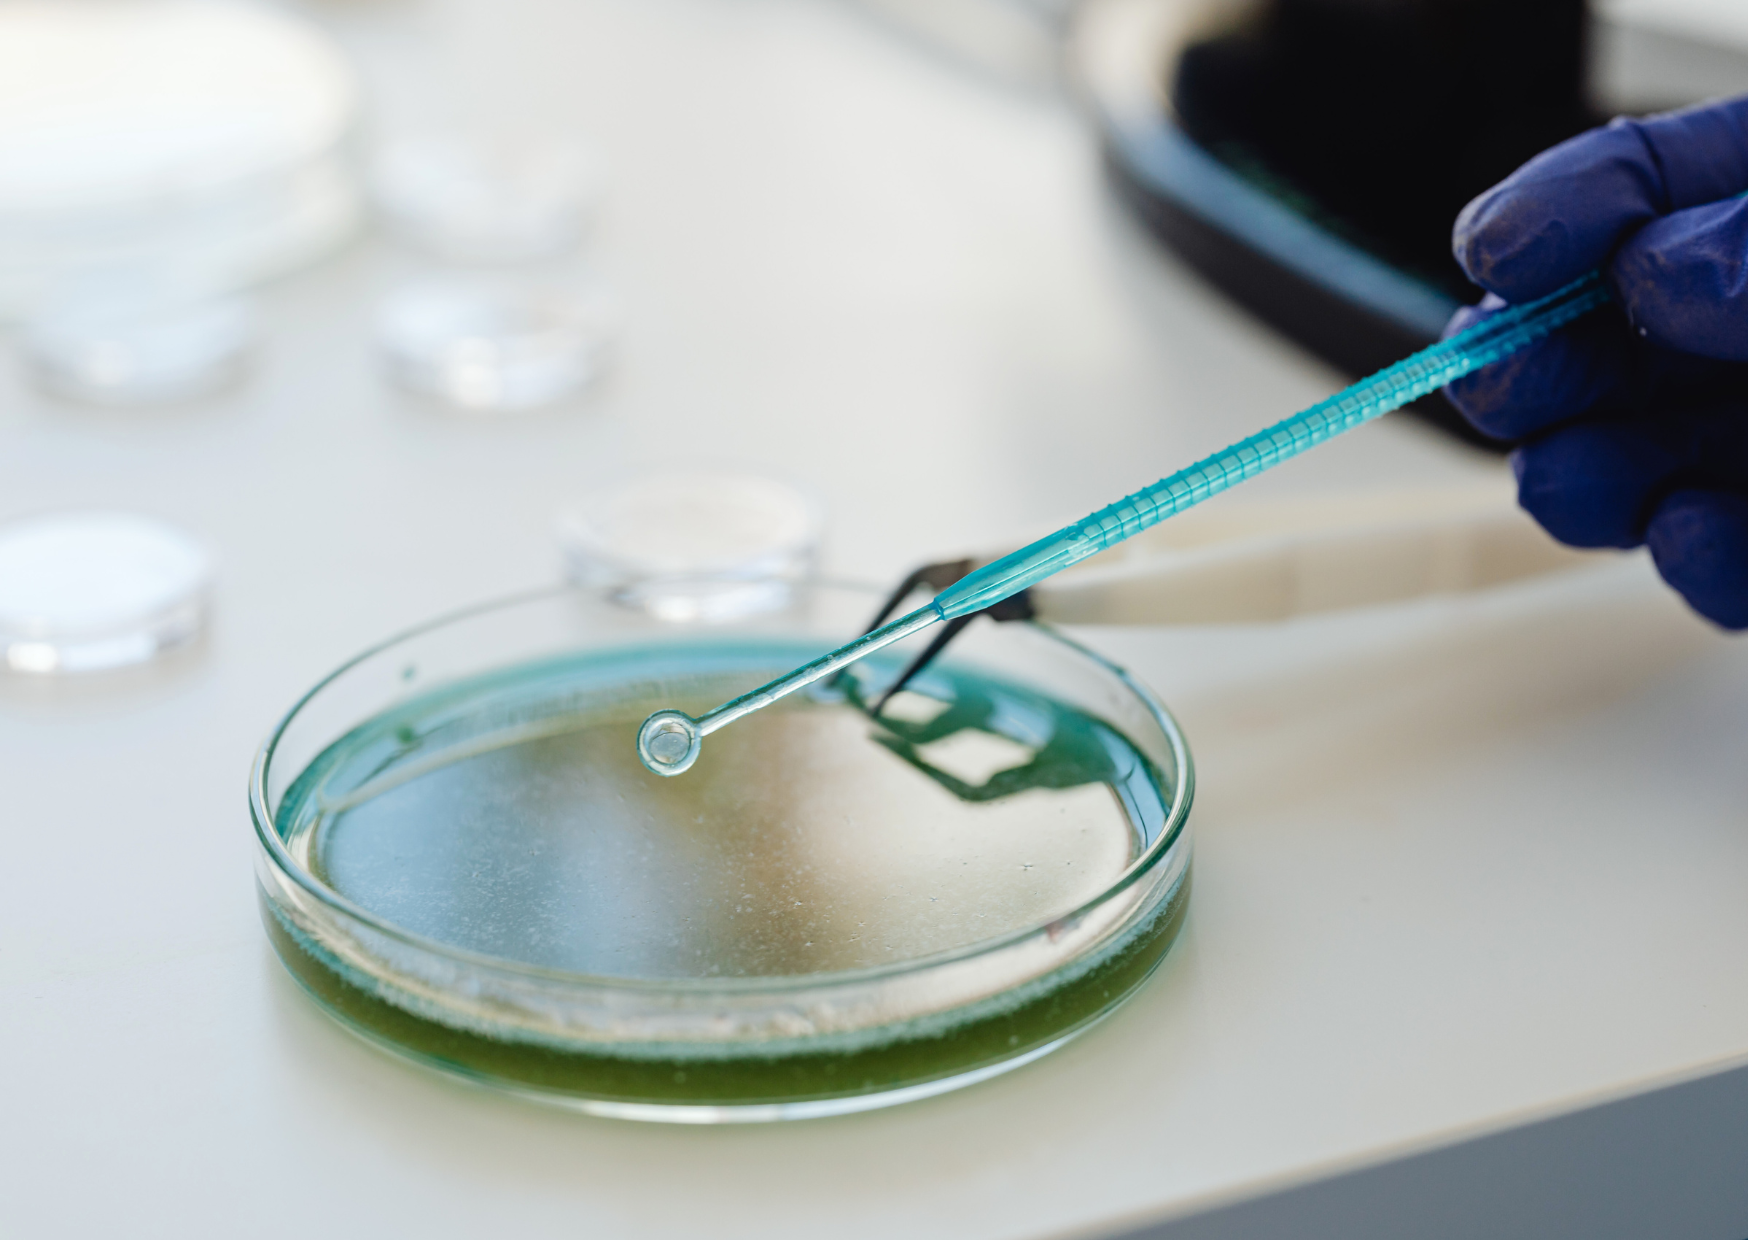
Projekt bez nazwy (7) postbiotyki

Na ludzkiej skórze bytują miliony mikroorganizmów określanych wspólnym mianem mikrobiomu. Stanowi on pierwszą linię obrony przed patogenami i niekorzystnymi czynnikami zewnętrznymi, a także pomaga zachować odpowiednie pH skóry.

Prawidłowe funkcjonowanie mikrobiomu jest niezbędne dla utrzymania zdrowej skóry, a wszelkie zaburzenia jego równowagi mogą prowadzić do pogorszenia się jej stanu i skutkować wystąpieniem podrażnień, suchości, zmian trądzikowych, a nawet oznak przyspieszonego starzenia.
Co to są postbiotyki?
Postbiotyki to otrzymywane mikrobiologicznie składniki pozyskiwane z nieżywych mikroorganizmów bądź ich metabolitów, które wykazują korzystny wpływ na organizm, w tym także skórę. Efekt ich działania jest podobny do probiotyków.
W przeciwieństwie do probiotyków, które są żywymi mikroorganizmami, postbiotyki są nieożywione, ale zachowują swoją aktywność biologiczną. W praktyce oznacza to, że postbiotyki są bardziej stabilne, nie wymagają specjalnych warunków i są łatwiejsze w recepturowaniu a jedocześnie posiadają korzystne oddziaływanie na skórę.
Podział postbiotyków
Wśród postbiotyków możemy wyróżnić (przykłady postbiotyków):
- produkty powstałe w wyniku fermentacji przeprowadzanej przez bakterie (zwykle z rodzaju Lactobacillus lub Bifidobacterium) czy drożdże. Otrzymane w rezultacie tego procesu metabolity, takie jak kwas mlekowy czy peptydy zapewniają skórze odpowiedni poziom nawilżenia, uelastyczniają ją i poprawiają jej ogólną kondycję. Przykładami fermentów o działaniu postbiotycznym są Bacillus Ferment Filtrate Extract oraz Saccharomyces Ferment Filtrate,
- lizaty bakteryjne – produkty uwalniane w wyniku rozpadu komórek bakteryjnych, w skład których wchodzą fragmenty ścian komórkowych, peptydy np. bakteriocyny czy polisacharydy. Składniki te łagodzą podrażnienia i działają regenerująco. Przykładami lizatów bakteryjnych są Bifida Ferment Lysate i Lactobacillus Ferment Lysate,
- oczyszczone metabolity bakteryjne – produkty wydzielane przez bakterie, w tym: kwasy organiczne (np. kwas mlekowy), peptydy (np. Sh-Oligopeptide-1, Acetyl Hexapeptide-8, Palmitoyl-Pantapeptide-4, kwas poliglutaminowy), enzymy (peroksydaza, dysmutaza ponadtlenkowa, proteazy), polisacharydy (cyklodekstryny, egzopolisacharydy),
- rozfragmentowane komórki bakteryjne – fragmenty ścian komórkowych (liposacharydy, peptydoglikany) i cytoplazmy.
Działanie postbiotyków
W ostatnich latach zaobserwowano znaczny wzrost zainteresowania postbiotykami w branży kosmetycznej. Są one coraz częściej wykorzystywanymi surowcami w kosmetykach ze względu na szereg korzystnych właściwości:
- wzmacniają barierę hydrolipidową skóry – wspierają produkcję ceramidów, lipidów i naturalnego czynnika nawilżającego (NMF), co ma wpływ na lepsze nawilżenie i mniejszą skłonność do podrażnień,
- wspierają naturalny mikrobiom skóry – ograniczają nadmierny wzrost mikroorganizmów patogennych i pomagają zachować równowagę mikrobiologiczną,
- łagodzą podrażnienia – wykazują właściwości przeciwzapalne, kojące i ochronne, co szczególnie pożądane jest w przypadku skóry trądzikowej, wrażliwej, podrażnionej czy w przebiegu takich schorzeń jak AZS,
- regenerują skórę – stymulują procesy naprawcze i odnowy komórkowej, przez co skóra szybciej się regeneruje.
Dla kogo przeznaczone są kosmetyki z postbiotykami?
Kosmetyki z postbiotykami dobrze sprawdzą się dla każdego rodzaju cery, ale szczególnie polecane są w przypadku:
- skóry suchej i odwodnionej,
- cery wrażliwej i nadreaktywnej,
- zaburzonej bariery hydrolipidowej,
- trądziku (młodzieńczego i dorosłego),
- skóry po intensywnych kuracjach z wykorzystaniem retinoidów, kwasów czy innych zabiegów estetycznych.
Postbiotyki w pielęgnacji
W okresie okołomenopauzalnym postbiotyki mogą być szczególnie wartościowym wsparciem dla skóry, ponieważ w tym czasie często staje się ona cieńsza, bardziej sucha, reaktywna i podatna na podrażnienia. Zmiany hormonalne wpływają również na mikrobiom skóry — jego różnorodność i stabilność mogą się obniżać.

Łagodzące serum przeciw zaczerwienieniom z linii More Than Pause stworzyliśmy z myślą o wymagającej cerze kobiet w okresie okołomenopauzalnym. Preparat zawiera unikalny postbiotyk pozyskiwany przy udziale bakterii z rodzaju Baciullus velezensis wyizolowanych z liści hyzopu lekarskiego (Hissopus officinalis). Składnik ten silnie regeneruje skórę, zmniejsza produkcję sebum, ogranicza skłonność do powstawania trądziku, łagodzi podrażnienia, wyrównuje koloryt cery, a także chroni przed powstawaniem przyspieszonych oznak starzenia.
Dzięki swojej stabilności i delikatności postbiotyki dobrze sprawdzają się w codziennej pielęgnacji każdego rodzaju skóry, także tej w okresie okołomenopauzalnym. Stanowią cenny składnik kosmetyków łagodzących, nawilżających i wzmacniających.

0 komentarzy